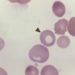

The two main surgical options for late-stage medial compartment osteoarthritis of the knee are partial knee replacement (PKR) and total knee replacement (TKR). There is significant variation in choice of approach among surgeons, likely because randomized controlled trials comparing the two approaches have not been performed. In this multicenter, randomized controlled trial, 528 patients with isolated osteoarthritis of the medial compartment of the knee were assigned to PKR or TKR to compare the clinical effectiveness of the two procedures measured by the Oxford Knee Score (OKS) 5 years after randomization. The OKS is a patient self-reported outcome questionnaire that was specifically developed to assess function and pain after knee replacement surgery. Health-care costs and cost-effectiveness were also assessed. Researchers found no difference in OKS between the two study groups at 5 years (mean difference 1.04, 95% CI -0.42 to 2.50; p=0.159). Moreover, there was no difference in patient satisfaction between the two groups at 5 years (82% satisfied with knee in PKR group vs. 77% in TKR group, RR 1.06, 95% CI 0.99 to 1.13, p=0.097). Patients receiving TKR had more complications than those receiving PKR (27% vs. 20%, respectively, RR 0.72, 95% CI 0.53 to 0.98; p=0.036). Finally, researchers found that PKR was more effective (0.240 additional QALYs as compared to TKR, 95% CI 0.046 to 0.434) and less expensive (-910£, 95% CI -1503£ to -317£) than TKR during the 5 years of follow-up. Limitations of this study include the absence of masking and the fact that the number of participants who completed follow-up was slightly less than the target of 500 participants required to reach adequate power. In summary, this study indicates that both TKR and PKR offer similar clinical outcomes, but overall suggests that PKR should be considered the first choice for patients with late-stage isolated medial compartment osteoarthritis given its superior cost-effectiveness.
Click to read the study in Lancet
Image: PD
©2019 2 Minute Medicine, Inc. All rights reserved. No works may be reproduced without expressed written consent from 2 Minute Medicine, Inc. Inquire about licensing here. No article should be construed as medical advice and is not intended as such by the authors or by 2 Minute Medicine, Inc.